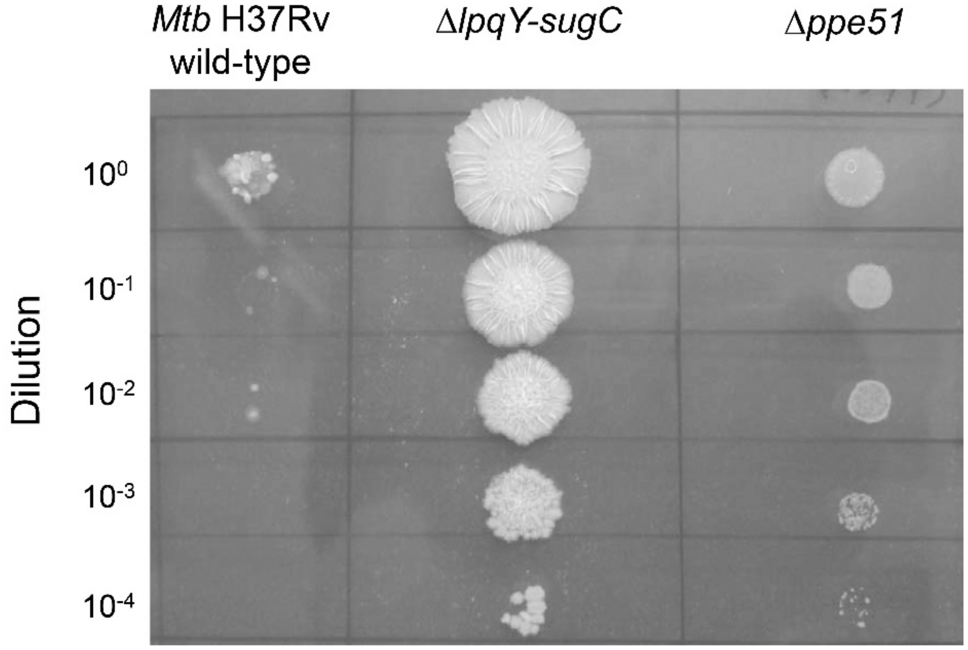
Figure 3

Figure 3
From: PPE51 mediates uptake of trehalose across the mycomembrane of Mycobacterium tuberculosis
6-TreAz resistance of the Mtb Δppe51 deletion mutant. 10 µl aliquots of tenfold-serially diluted cell suspensions of Mtb H37Rv wild-type, the ΔlpqY-sugC gene deletion mutant and the Δppe51 gene deletion mutant were spotted onto Middlebrook 7H10 agar containing 1 mM 6-TreAz and incubated for 3 weeks at 37 °C. The Δppe51 gene deletion mutant is unable to utilize glucose as will be demonstrated in Fig. 4 and therefore exhibits a growth defect on the used solid medium that contains glycerol and glucose as main carbon sources.